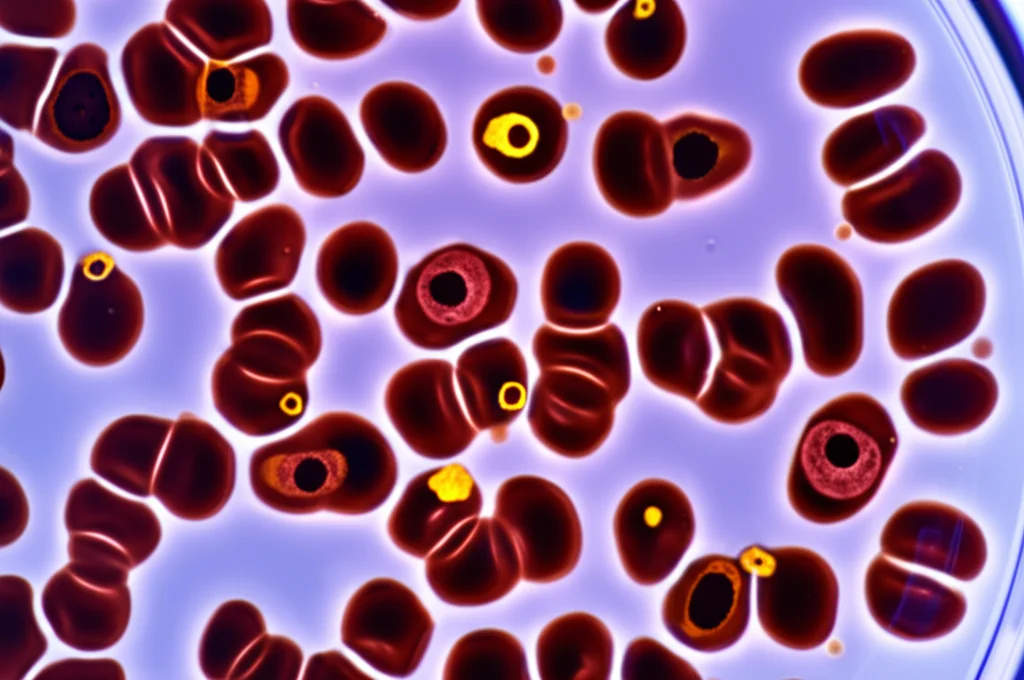
Fotografia macro di cellule del sangue equine in una piastra di Petri, alcune luminose a indicare stress ossidativo, altre più scure trattate con astaxantina. Obiettivo macro 100mm, illuminazione controllata da laboratorio, alta definizione, messa a fuoco precisa.

Astaxantina: Il Carburante Segreto per la Potenza dei Cavalli da Corsa Arabi?
Ciao a tutti gli appassionati di cavalli e di scienza! Oggi voglio portarvi nel mondo affascinante dei cavalli da corsa Arabi, atleti straordinari che richiedono cure e attenzioni particolari per mantenersi al top della forma. Vi siete mai chiesti cosa succede a livello cellulare quando questi magnifici animali si spingono al limite? E se ci fosse un modo naturale per aiutarli a gestire lo stress e l’infiammazione, migliorando recupero e performance? Beh, sembra proprio di sì, e la risposta potrebbe trovarsi in un pigmento rosso-arancio chiamato astaxantina.
Recentemente mi sono imbattuto in uno studio scientifico davvero interessante (trovate il link alla fine!) che ha esplorato proprio questo: gli effetti dell’integrazione di astaxantina nei cavalli da corsa Arabi. E i risultati, lasciatemelo dire, sono piuttosto promettenti!
Lo Stress Ossidativo e l’Infiammazione: Nemici Silenziosi dei Cavalli Atleti
Immaginate i muscoli di un cavallo da corsa al lavoro: un’incredibile macchina metabolica che brucia energia a ritmi elevatissimi. Questo sforzo intenso, però, ha un prezzo. Produce una grande quantità di “scorie” metaboliche note come specie reattive dell’ossigeno (ROS), i famosi radicali liberi. Quando i ROS superano le capacità antiossidanti naturali del corpo, si crea uno stato di stress ossidativo.
Pensate allo stress ossidativo come a una sorta di “ruggine” cellulare. Danneggia le componenti fondamentali delle cellule – lipidi, proteine, DNA – e innesca una risposta immunitaria: l’infiammazione. Un po’ di infiammazione è normale e utile per la riparazione, ma quando diventa eccessiva o cronica, specialmente nei cavalli atleti, può portare a:
- Dolore e rigidità muscolare
- Ridotta funzionalità muscolare
- Tempi di recupero più lenti
- Maggiore suscettibilità a infortuni e malattie
- Affaticamento cronico
Insomma, stress ossidativo e infiammazione sono strettamente legati e possono compromettere seriamente la salute e le prestazioni dei nostri amici equini. Gestirli è fondamentale.
Entra in Scena l’Astaxantina: Un Antiossidante Naturale con i Superpoteri
Qui entra in gioco l’astaxantina. È un carotenoide naturale, lo stesso pigmento che dà il colore rosa a salmoni e gamberetti, prodotto principalmente da microalghe. La sua struttura chimica unica la rende un antiossidante eccezionalmente potente, molto più efficace di altri noti antiossidanti nel neutralizzare i radicali liberi e proteggere le cellule.
Nello studio che ho letto, i ricercatori hanno prima lavorato *in vitro*, cioè in laboratorio, usando cellule specifiche del sistema immunitario dei cavalli (le cellule mononucleate del sangue periferico, o PBMC). Hanno indotto artificialmente stress ossidativo in queste cellule usando perossido di idrogeno (H₂O₂) – un modo per simulare ciò che accade durante uno sforzo intenso.
I risultati? Le cellule trattate con H₂O₂ mostravano, come previsto, un aumento dei ROS e l’attivazione di geni e proteine infiammatorie chiave (citochine come IL-1β, IL-6, IFN-γ, TNF-α). Ma ecco la parte interessante: quando a queste cellule stressate veniva aggiunta l’astaxantina, si osservava una riduzione significativa sia dei ROS che delle citochine pro-infiammatorie! Non solo: l’astaxantina sembrava anche “preparare” le cellule a difendersi meglio, aumentando l’espressione di geni legati alle difese antiossidanti (come NRF1, SOD2, GPX). Un primo indizio davvero incoraggiante!
Il Colpo di Scena: L’Astaxantina Potenzia la “Pulizia Cellulare” (Mitofagia)
Ma la scoperta forse più affascinante dello studio riguarda un processo cellulare chiamato mitofagia. Mai sentito? È un meccanismo fondamentale con cui le nostre cellule (e quelle dei cavalli!) si sbarazzano dei mitocondri danneggiati. I mitocondri sono le “centrali energetiche” della cellula, ma quando sono vecchi o danneggiati, diventano una delle principali fonti di ROS e possono alimentare l’infiammazione.
La mitofagia è, in pratica, il sistema di riciclaggio selettivo dei mitocondri. Identifica quelli difettosi e li elimina, mantenendo così una popolazione di mitocondri sani ed efficienti. Questo è cruciale per ridurre lo stress ossidativo alla fonte e mantenere la produzione di energia ottimale.
Ebbene, lo studio ha condotto anche una sperimentazione *in vivo*, su veri cavalli da corsa Arabi. Un gruppo di cavalli ha ricevuto un’integrazione orale giornaliera di astaxantina per 10 settimane, mentre un gruppo di controllo ha ricevuto un placebo. Analizzando le cellule PBMC prelevate dai cavalli nel tempo, i ricercatori hanno scoperto qualcosa di straordinario: nei cavalli che assumevano astaxantina, c’era un aumento significativo dell’espressione di geni chiave per la mitofagia, in particolare PINK1 e PARKIN!
Questi geni sono come i “controllori di qualità” dei mitocondri. Quando un mitocondrio è danneggiato, PINK1 si accumula sulla sua superficie e “chiama” PARKIN, che lo etichetta per la distruzione. Un aumento di questi geni suggerisce che l’astaxantina stia potenziando attivamente questo processo di pulizia cellulare nei cavalli. È un meccanismo d’azione potentissimo: non solo l’astaxantina combatte i ROS direttamente, ma aiuta anche la cellula a eliminare la fonte stessa dei ROS!
Non Solo Mitofagia: Un Supporto a 360° per i Mitocondri
Ma non è finita qui! L’integrazione con astaxantina ha mostrato di influenzare positivamente anche altri aspetti della salute mitocondriale:
- Dinamica Mitocondriale: Aumento dell’espressione di geni come MIEF1 e PIGBOS, coinvolti nella corretta struttura, fusione e comunicazione dei mitocondri con altre parti della cellula.
- Produzione Energetica: Incremento di geni come PPARGC1B e NDUFA9, legati all’efficienza della produzione di ATP (la “moneta energetica” della cellula) e alla protezione dallo stress ossidativo a livello mitocondriale.
- Funzione e Struttura del DNA Mitocondriale: Aumento di geni come MRPL24, PUSL1 e TFAM, essenziali per la corretta traduzione delle proteine mitocondriali e la gestione del DNA mitocondriale stesso.
In pratica, l’astaxantina sembra fornire un supporto completo alla funzionalità mitocondriale, rendendo le cellule più resilienti, efficienti dal punto di vista energetico e capaci di gestire meglio lo stress.

Cosa Significa Tutto Questo per i Nostri Cavalli?
Mettendo insieme i pezzi, questo studio suggerisce fortemente che l’integrazione con astaxantina possa essere un valido aiuto per i cavalli da corsa Arabi (e potenzialmente per altri cavalli atleti). Riassumendo i benefici osservati:
- Azione Antiossidante Diretta: Neutralizza i radicali liberi.
- Azione Antinfiammatoria: Riduce le citochine pro-infiammatorie indotte dallo stress.
- Potenziamento delle Difese Antiossidanti Endogene: Stimola l’espressione di geni protettivi.
- Miglioramento della Salute Mitocondriale: Potenzia la mitofagia (eliminazione dei mitocondri danneggiati) e supporta la dinamica, la produzione energetica e la funzione generale dei mitocondri.
Tutto ciò si traduce potenzialmente in una maggiore resilienza allo stress ossidativo e all’infiammazione, un recupero più rapido dopo l’esercizio intenso e, di conseguenza, un possibile miglioramento delle performance e del benessere generale.
Certo, come sottolineano gli stessi ricercatori, sono necessarie ulteriori ricerche per approfondire alcuni aspetti e confermare questi risultati su scala più ampia. Bisogna anche considerare che ogni specie animale può rispondere diversamente. Tuttavia, i dati presentati sono decisamente promettenti e aprono una strada interessante per l’uso dell’astaxantina come integratore alimentare mirato a supportare la salute cellulare e le prestazioni dei cavalli atleti.
Personalmente, trovo affascinante come un composto naturale possa avere un impatto così profondo a livello molecolare, aiutando questi splendidi animali a dare il meglio di sé in modo più sano. È un esempio perfetto di come la scienza possa svelare i segreti della natura a beneficio dei nostri compagni animali.
E voi, conoscevate l’astaxantina e i suoi potenziali benefici? Fatemi sapere cosa ne pensate!

Fonte: Springer
